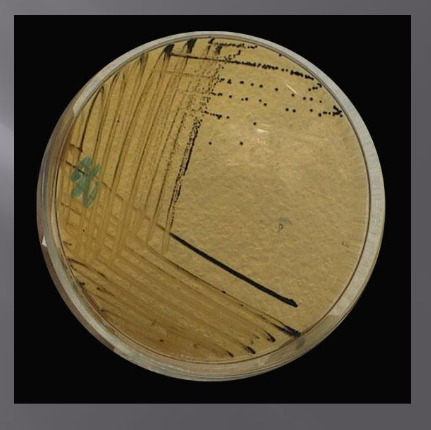
<ul><li><p>принадлежи към сем. Enterobacteriaceae</p></li><li><p>факултативни анаероби</p></li><li><p>Ферментиращи глюкоза, манитол и сорбитол</p></li><li><p>грам-отрицателни пръчици</p></li><li><p>перитрихи с изключение на S. pallinarum→подвижни</p></li><li><p>Не образуват същински капсули</p></li><li><p>нямат спори</p></li><li><p>под въздействие на химични, физични и биологични фактори могат да променят морфологията си и да придобият нишковидна или коковидна форма, да загубят ресните си(полиморфни)</p></li><li><p>невзискателни</p></li><li><p><span><span>върху диференциращите<br>хранителни среди образуват лактозонегативни<br>колонии, върху селективните хранителни среди<br>образуват колонии с черен център, поради<br>продукцията на H2S<br></span></span></p></li></ul><p></p>
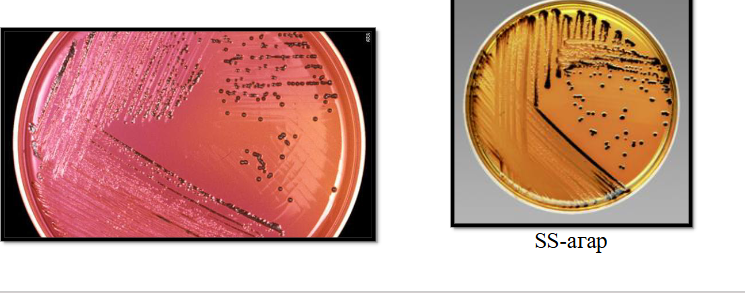
<ul><li><p>културелно изследване</p></li><li><p><span><span>биохимична идентификация→глюкозо-положителни, лактозо-отрицателни, образуват газ и киселина, сероводород +,не притежават уреаза</span></span></p></li><li><p><span><span>серологична идентификация→пробна аглутинация тип Грубер/Видал</span></span></p></li></ul><p></p>

Род Salmonella
1/11
There's no tags or description
Looks like no tags are added yet.
Name | Mastery | Learn | Test | Matching | Spaced |
|---|
No study sessions yet.
12 Terms

Какво е характерно за Род Salmonella?
принадлежи към сем. Enterobacteriaceae
факултативни анаероби
Ферментиращи глюкоза, манитол и сорбитол
грам-отрицателни пръчици
перитрихи с изключение на S. pallinarum→подвижни
Не образуват същински капсули
нямат спори
под въздействие на химични, физични и биологични фактори могат да променят морфологията си и да придобият нишковидна или коковидна форма, да загубят ресните си(полиморфни)
невзискателни
върху диференциращите
хранителни среди образуват лактозонегативни
колонии, върху селективните хранителни среди
образуват колонии с черен център, поради
продукцията на H2S
Антигенна структура:
соматични (О) и флагеларни-Н антигени
някои Vi-антиген, които имат ди агностично значение(S. typhi)
Фактори на патогенност:
повърхностните структури (О-полизахаридни вериги, ЛПЗ като ендотоксин, Н и Vi)
фактори на адхеренцията и инвазията, ентеротоксини и цитотоксини
Причинители на тифно-паратифни заболявания:
S. typhi→коремен тиф
паратиф А и В
Коремен тиф:
свързана с лоша хигиена
антропоноза
механизъм на предаване – фекално-орален
входна врата – уста, лигавица на тънкото черво
Инк.пер.-7-21дни
Клинични прояв на коремен тиф:
стъпаловидно повишаване на температурата до 39-40 градуса, отпадналост, главоболие, безапетитите, болки в корема
замъгляване на съзнанието с бълнуване (status typhosus)
розеоло-петехиален
обрив и диария
Материали за изследване:Тифо-паратифни заболявания
1ва седмица – кръв и костен мозък
2ра и 3та седмица – кръв + фецес, урина, жлъчка
рачка, ликвор, гной
Причинители на хранителни токсоинфекции:
S. enteritidis, S. typhimurium- у нас
S. choleraesuis
Хранителни токсоинфекции(салмонелози):
Основният механизъм за предаване на заразата при човека е алиментарният
чрез консумация на заразени хранителни
продуктигастроентеритите са самоограничаващи се инфекции –преминава в рамките на 2-5 дни и не се налага лечение.
при малки деца и стари хора може да протече по-тежко – дехидратация,нарушено електролитно и алкално-киселинно равновесие

Материал за изследване:Хранителни
токсикоинфекции
фецес
Лбораторна диагностика:
културелно изследване
биохимична идентификация→глюкозо-положителни, лактозо-отрицателни, образуват газ и киселина, сероводород +,не притежават уреаза
серологична идентификация→пробна аглутинация тип Грубер/Видал
Специфична профилактика и лечение:
Има противотифна ваксина.За лечение хлорамфеникол,
ампицилин, амоксицилинза салмонелозите няма специфична профилактика, нито се прилагат антибиотици – тя е самоограничаваща се инфекция